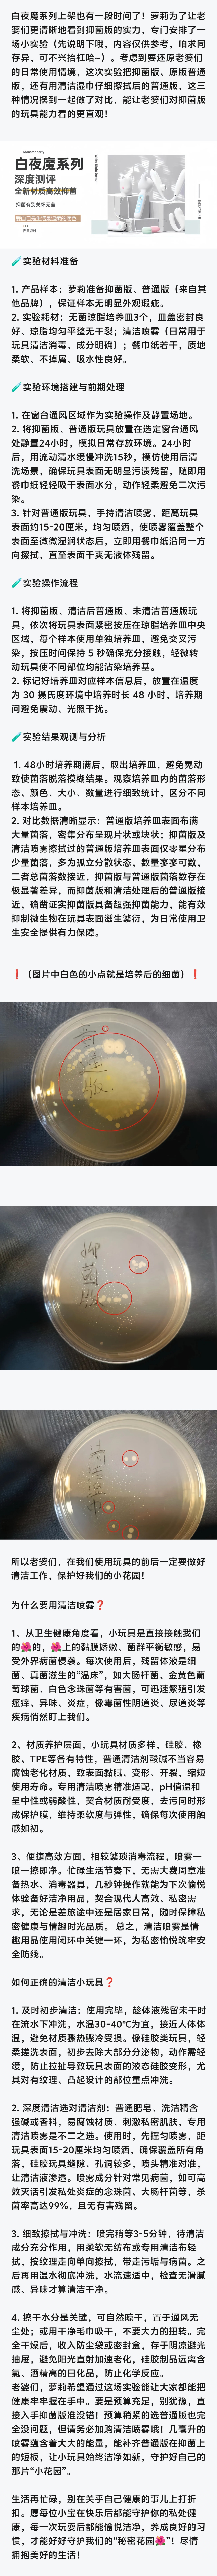

精致女孩👧一定要知道的养护㊙️
2025年11月12日
【怪兽女孩测评】
作者:萝莉的魔法
id:84244
136阅读
2赞
小怪兽优选